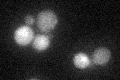
YLR136C
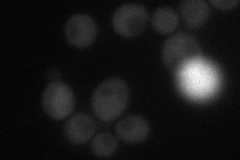
YLR136C
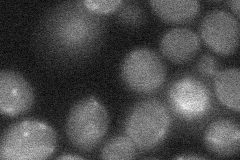
YLR136C
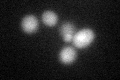
YLR136C
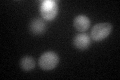
YLR136C
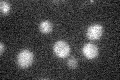
YLR136C

View description
mRNA-binding protein expressed during iron starvation; binds to a sequence element in the 3'-untranslated regions of specific mRNAs to mediate their degradation; involved in iron homeostasis
Localization:
Intensity:
Fold change:
Significance:
-
C’ GFP library in SD
cytosol27.56 -
N' NOP1pr-GFP in SD
cytosol34.4944 -
N' TEF2pr-mCherry in SD

below threshold322.83 -
N' NATIVEpr-GFP in SD

cytosol27.9219 -
N' TEF2pr-VC and Cyto-VN in SD
below threshold22.6978 -
C’ GFP library in SD+DTT
cytosol35.541.28No -
C’ GFP library in SD+H2O2
cytosol55.812.02Yes -
C’ GFP library in Starvation Media
cytosol20.540.74No -
C’ GFP library on the background of Pup2-DaMP

cytosol -
C’ GFP library on the background of CCT mutant

cytosol24.19320.877615No
